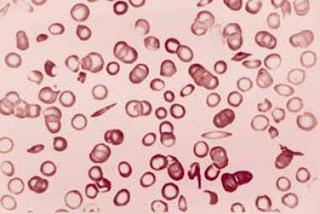
Transfusion préopératoire comme alternative dans l’anémie à hématies falciformes (Étude TAPS) : un essai multicentrique randomisé et contrôlé

Frottis sanguin: hématies falciformes. In Annales de Cardiologie et d'Angéiologie Volume 61, Issue 5, Novembre 2012, Pages 382 - 385
Source iconographique et légendaire: http://www.sciencedirect.com/science/article/pii/S0003392812001187
Il n’existe pas de consensus permettant de définir si les transfusions préopératoires sont d’un bénéfice significatif aux patients atteints d’anémie à hématies falciformes. Le but de la présente étude était l’étude des risques péropératoires d’une transfusion préopératoire.
Nous avons entrepris un essai multicentrique randomisé. Les patients éligibles étaient âgés d’au moins un an, et montraient les sous-types d’hémoglobine SS thalassémie ou thalassémie SBO dans leur tableau de pathologie d’anémie à hématies falciformes; et ont été par conséquent planifiés pour opération à faible risque ou opération à risque moyen, selon le cas. Le paramètre principal évalué était l’apparition de complications cliniques importantes entre Jrandomisationet Jchirurgie + 30. L’analyse a été effectuée sur population en intention de traiter.
67 (96%) des 70 patients recrutés – 33 sans transfusion préopératoire et 34 avec transfusion préopératoire – ont été étudiés. 65 (97%) des 67 patients étaient porteurs d’une hémoglobine de sous-type SS et 54 (81%) ont été planifiés pour subir une chirurgie à risque moyen. 13 (39%) des 33 patients du groupe sans transfusion préopératoire ont montré d’importantes complications cliniques, en comparaison des 5 (15%) du groupe ayant subi la transfusion préopératoire. De ceux-là, 10 (30%) et un (3%) respectivement ont montré des évènements indésirables graves. Le quotient de probabilité non ajusté de complications cliniques importantes était de 3,8 (Intervalle de Confiance – IC – 1,2-12,2 ; p=0,027). 10 (91%) des évènements indésirables graves étaient syndrome thoracique aigu (neuf dans le groupe sans transfusion préopératoire et un dans le groupe avec transfusion préopératoire). La durée du séjour à l’hôpital ainsi que les taux de réadmission n’ont pas montré de différence intergroupe.
La transfusion préopératoire a été associée à une diminution des complications péropératoires chez les patients atteints d’anémie à hématies falciformes. Cette approche pourrait donc être bénéficiaire aux patients porteurs d’hémoglobine de sous – type SS planifiés pour subir des chirurgies classées à faible risque ou à risque moyen. Dr Jo Howard FRCPath et al, in The Lancet, Early Online Publication 23 January 2013, in press
Financement: NHS (National Health Service) Blood and Transplant
Source: The Lancet Online / Traduction et adaptation: NZ
